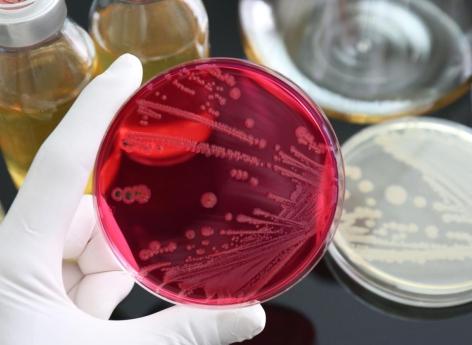

Infection bactérienne
Intoxication alimentaire : comment la salmonelle trompe les défenses immunitaires ?
Des chercheurs ont mis en évidence comment la bactérie Salmonella - l’une des causes principales d’intoxication alimentaire - parvient à se multiplier dans l'organisme et à échapper au système immunitaire.
- Par Mégane Fleury
- Commenting
- Ca-ssis/istock
La salmonellose touche des centaines de milliers de personnes chaque année en France. Selon Santé Publique France, cité par l’Institut Pasteur, 198.000 cas de cette infection bactérienne seraient recensés tous les ans, dont 183.000 sont d’origine alimentaire.
Aux États-Unis, des chercheurs ont voulu comprendre comment la bactérie Salmonella parvenait à échapper au système immunitaire. Ils présentent leurs résultats dans Proceedings of the National Academy of Sciences.
Comment la salmonelle perturbe l’équilibre nutritionnel dans l’intestin ?
Comme les scientifiques le rappellent, le système digestif abrite des milliards de bactéries, dont beaucoup produisent des acides gras à chaîne courte (AGCC) qui aident à combattre les pathogènes nocifs. En toute logique, en présence de ces outils de protection, la bactérie ne devrait pas réussir à se reproduire. Andreas Bäumler, professeur à l'UC Davis en Californie et vice-président de la recherche au département de microbiologie médicale et d’immunologie, et son équipe ont découvert que le pathogène modifie l’équilibre nutritionnel de l’intestin. "Lorsque la salmonelle pénètre dans l’intestin grêle, elle provoque une inflammation de la muqueuse intestinale et perturbe l’absorption normale des acides aminés des aliments, développent-ils. Cela crée un déséquilibre des nutriments dans l’intestin." Or, cela permet à la bactérie d’obtenir les ressources nécessaires pour survivre et se multiplier dans le gros intestin, où les bactéries présentes freinent généralement sa croissance.
Les chercheurs ont obtenu ces résultats après un essai sur des souris. Ils ont suivi l’absorption des acides aminés dans l’intestin grêle et le gros intestin. Cela leur a permis de découvrir que chez les souris infectées par la salmonelle, l’absorption des acides aminés dans le sang était moindre. "En fait, deux acides aminés, la lysine et l’ornithine, sont devenus plus abondants dans l’intestin après l’infection, observent-ils. Ces acides aminés ont aidé la salmonelle à survivre en empêchant les effets inhibiteurs de croissance des AGCC." L’équipe scientifique montre que la salmonelle utilise ses propres "facteurs de virulence", c’est-à-dire les molécules provoquant des maladies, pour activer des enzymes qui décomposent des acides aminés clés comme la lysine. "Cela aide le pathogène à éviter les effets protecteurs des AGCC et à se développer plus facilement dans l’intestin", précisent-ils.
Maladies digestives : l’importance d’un microbiote intestinal en bonne santé
Ces chercheurs de l'UC Davis estiment que cette découverte pourrait fournir des explications à certains troubles caractérisés par des déséquilibres de l’environnement intestinal, comme la maladie de Crohn ou la colite ulcéreuse. À terme, cela pourrait permettre de développer de nouveaux traitements pour protéger le microbiote intestinal.
"Cette recherche (…) nous permet non seulement de mieux comprendre le fonctionnement de la bactérie Salmonella, mais elle souligne également l’importance de maintenir un microbiote intestinal sain, souligne Lauren Radlinski, autrice principale de l’étude. Nos découvertes pourraient conduire à de nouveaux traitements qui aident à soutenir le microbiote pendant l’infection."


























